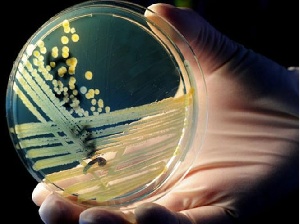
Массовый падеж коров в Приаргунском районе связан с отравлением химическим элементом

Новости отрасли

|
Массовый падеж коров в Приаргунском районе связан с отравлением химическим элементом
Отравление химическим элементом. Стали известны первые результаты анализов с места массового падежа коров в поселке Кличка Приаргунского района. Напомним, произошло это в начале мая. Мы продолжаем следить за развитием ситуации.
В один день по неизвестным причинам пало сразу восемь голов крупного рогатого скота. Местные жители подозревают, что виной всему деятельность запущенной недавно в строй горно-обогатительной фабрики, якобы ее реагентами отравились буренки. У погибших животных наблюдалось обильное кровотечение и лопались глаза. В тот же день на месте происшествия побывали представители ветеринарной службы они отобрали патологический материал. И вот результаты исследований.
Дмитрий Гладких, главный ветеринарный врач Приаргунского района: "Отобран был он от двух голов, в связи с тем, что все животные были павшими с патологоанатомическими признаками, направлен был в забайкальскую краевую ветеринарную лабораторию. Пришел результат - там обнаружено повышенное содержание мышьяка".
Кстати, стоит отметить, что мышьяк и сурьма - элементы одной азотной химической подгруппы, а на фабрике, что находится в Кличке, обогащают именно сурьму. Пока анализ подтвердил, что причиной гибели животных стал химический элемент. Теперь остается найти источник его распространения.
В один день по неизвестным причинам пало сразу восемь голов крупного рогатого скота. Местные жители подозревают, что виной всему деятельность запущенной недавно в строй горно-обогатительной фабрики, якобы ее реагентами отравились буренки. У погибших животных наблюдалось обильное кровотечение и лопались глаза. В тот же день на месте происшествия побывали представители ветеринарной службы они отобрали патологический материал. И вот результаты исследований.
Дмитрий Гладких, главный ветеринарный врач Приаргунского района: "Отобран был он от двух голов, в связи с тем, что все животные были павшими с патологоанатомическими признаками, направлен был в забайкальскую краевую ветеринарную лабораторию. Пришел результат - там обнаружено повышенное содержание мышьяка".
Кстати, стоит отметить, что мышьяк и сурьма - элементы одной азотной химической подгруппы, а на фабрике, что находится в Кличке, обогащают именно сурьму. Пока анализ подтвердил, что причиной гибели животных стал химический элемент. Теперь остается найти источник его распространения.
Источник:
http://chita.rfn.ru


